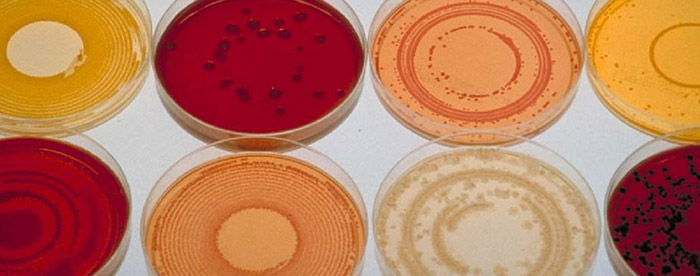
CBD posiada działanie antybakteryjne

W miarę jak legalizacja marihuany medycznej postępuje coraz sprawniej masowo spływają wyniki badań nad CBD – aktywnym, leczącym składnikiem konopi. Przynoszący ulgę na wielu polach, legalny i coraz szerzej dostępny to właśnie CBD jest najbardziej fascynującym składnikiem konopi. CBD należy do grupy ok. 60, w tym 2 głównych (obok THC), kannabinoidów które znajdziemy w roślinach cannabis …
Jak CBD może ci pomóc? 8 realnych zastosowań

W miarę jak legalizacja marihuany medycznej postępuje coraz sprawniej masowo spływają wyniki badań nad CBD – aktywnym, leczącym składnikiem konopi. Przynoszący ulgę na wielu polach, legalny i coraz szerzej dostępny to właśnie CBD jest najbardziej fascynującym składnikiem konopi.
CBD należy do grupy ok. 60, w tym 2 głównych (obok THC), kannabinoidów które znajdziemy w roślinach cannabis sativa L. W przeciwieństwie do THC, CBD nie jest psychoaktywny, czyli nie powoduje uczucia „haju”, a dziś uznaje się go jako substancję mogącą zrewolucjonizować rynek medycyny naturalnej.
Jeśli słyszałeś o CBD, ale jeszcze nie wiesz w jaki sposób może on pozytywnie wpłynąć na twoje zdrowie i samopoczucie, oto 8 przykładów skutecznych zastosowań:

Mięśnie, stawy, organy ciała
CBD wspiera prawidłowe funkcjonowanie mięśni, stawów i organów ciała, zmniejszając ryzyko zapadania na choroby reumatyczne i inne choroby związane z pracą układu odpornościowego i powodowanymi przez nie zapaleniami.

Stany lękowe i depresja
Za walkę z depresją, stanami lękowymi, brakiem apetytu i ogólne poczucia szczęścia i zadowolenia odpowiada w dużej mierze układ endokannabinoidowy, rolą układu endokannabinoidowego jest pośrednie wpływanie na pamięć, nastrój, aktywność motoryczną i podatność na uzależnienia. CBD wpływa na receptory układu ECS, tym samym zwiększając pracę i wspierając regulację powiązań neurohormonalnych.

Uczucie łaknienia u chorych
Jedną z najbardziej uciążliwych dolegliwości u pacjentów zapadających na różne choroby jest znaczna utrata apetytu. Chorzy przechodzący chemioterapię często całkowicie tracą uczucie łaknienia, co dodatkowo wyczerpuje i tak już niskie zasoby energii. Wiele leków działa na układ endokannabinoidowy zaburzając uczucia sytości i głodu. Od dawna wiadomo, że CBD pobudza apetyt regulując sprawne działanie układu. Prawidłowe odżywianie w chorobie może być krokiem wprzód do dalszego powrotu do zdrowia.

Choroby neurodegeneracyjne mózgu
Prawie 44 mln ludzi na całym świcie cierpi na chorobę Alzheimera, w tym 2 na 3 osoby to kobiety. Choroba Alzheimera, pląsawica Huntingtona czy stwardnienie rozsiane powodują nieodwracalne zmiany w mózgu. Dowiedziono jednak, że sprawne działanie układu endokannabinoidowego opóźnia ich rozwój. Pobudzając aktywność układu CBD oddala nas od groźnych chorób neurodegeneracyjnych.

Działanie przeciwpsychotyczne
Uważa się, że CBD redukuje psychotyczne działanie THC i może hamować nasilenie objawów związanych z różnymi typami psychozy. Dodatkowo, w przeciwieństwie do leków przeciwpsychotycznych, naturalny CBD nie niesie za sobą wyniszczających skutków ubocznych.

Starzenie się mózgu
Starzenie się mózgu to normalny proces, na który wpływ w dużej mierze ma działanie niespecyficznych reakcji wolnych rodników. Powstają one na drodze metabolizmu. Wolne rodniki, jako produkt tego co jemy i pijemy, są nie do uniknięcia. Ale według najnowszych badań CBD ma wspierać procesy usuwania wolnych rodników z mózgu, tym samym przedłużając jego sprawne działanie.

Pobudzenie szarych komórek
CBD pobudza działanie mitochondriów, będących nośnikiem energii dla komórek. Mitochondria pracują efektywniej również przy mniejszym nagromadzeniu wolnych rodników, w czym może pomóc CBD.
Działanie antybakteryjne
Uważa się, że CBD a tym samym produkowany z niego olejek konopny CBD, ma naturalne działanie antybakteryjne. Od lat 50-tych stosuje się go w leczeniu gruźlicy. Im bardziej odporne na leki stają się współczesne bakterie, tym większa rola naturalnych substancji w profilaktyce chorobowej. CBD wykazuje znaczące działanie antybakteryjne przeciw powszechnemu w USA gronkowcowi złocistemu odpornemu na metycylinę, który zabija 18 tyś z 94 tyś chorych rocznie.
Czy przekonaliśmy was, że pora zaopatrzyć domową apteczkę w naturalne preparaty na bazie CBD?
[cn-source text=”Clifford Genece, honeycolony.com”]





